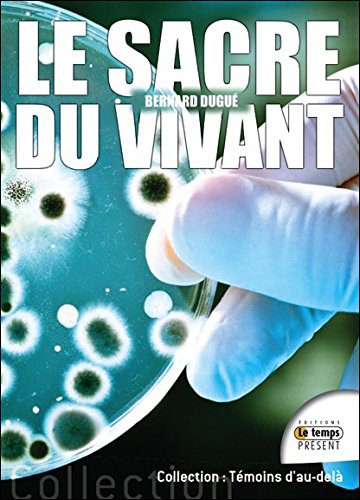
Le  sacre du vivant

Chargement...
| Auteur(s) : | Bernard Dugué |
|---|---|
| Collection : | Collection Science conscience |
| Editeur : | Éditions le Temps présent (FR Agnières) |
| Cette édition : | 2014 |
| Sous-titre : | essai post-darwinien sur l'essence de la vie et son évolution |
| Prix neuf : | 19.0 EUR |
| Code-barres : | 9782351851821 |
| Dimensions : | 22 cm |
| Volume : | 1 vol. (241 p.) |